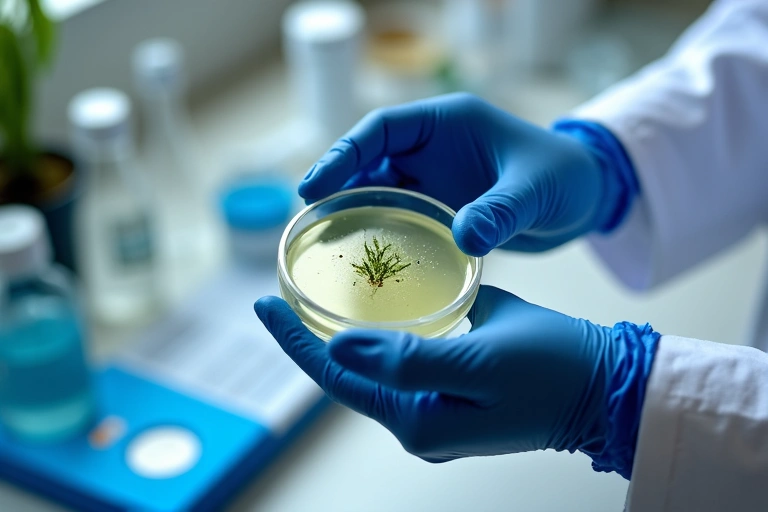

Nasza Historia i Filozofia
Poznaj wartości, które kierują Glucorownowaga w dążeniu do naturalnego zdrowia i harmonii. Wierzymy, że prawdziwe zdrowie zaczyna się od natury, a nasza misja to dostarczanie produktów, które wspierają równowagę w organizmie.

Początki Glucorownowaga
Historia Glucorownowaga rozpoczęła się od głębokiego przekonania, że natura oferuje potężne rozwiązania dla współczesnych wyzwań zdrowotnych. W świecie pełnym przetworzonej żywności i sztucznych dodatków, coraz więcej osób poszukuje naturalnych ścieżek do dobrego samopoczucia. Nasza firma powstała z potrzeby stworzenia suplementów diety, które nie tylko są skuteczne, ale przede wszystkim bezpieczne i oparte na sprawdzonych darach natury.
Założyciele Glucorownowaga, z pasją do fitoterapii i biochemii, połączyli siły, aby badać i rozwijać formuły, które wspierają kluczowe funkcje organizmu, koncentrując się szczególnie na utrzymaniu optymalnego poziomu glukozy we krwi. Od samego początku postawiliśmy na rygorystyczne badania naukowe, współpracę z ekspertami i wykorzystanie wyłącznie najwyższej jakości surowców. Nasza podróż rozpoczęła się w małym laboratorium, ale z wielkimi marzeniami o poprawie zdrowia i jakości życia ludzi na całym świecie.

Dziś, Glucorownowaga to uznana marka, która kontynuuje misję dostarczania innowacyjnych i naturalnych rozwiązań. Jesteśmy dumni z naszych korzeni i wartości, które towarzyszą nam na każdym etapie rozwoju produktu – od koncepcji, przez badania, aż po finalny produkt trafiający w ręce naszych klientów. Wierzymy, że każdy zasługuje na dostęp do naturalnych metod wspierania zdrowia, a naszą rolą jest uczynienie ich dostępnymi i zrozumiałymi.
Nasza Filozofia
Natura na Pierwszym Miejscu
Wierzymy w niezrównaną moc natury i jej zdolność do wspierania organizmu w dążeniu do równowagi i zdrowia. Każdy nasz produkt to hołd dla bogactwa roślin, minerałów i składników odżywczych, które oferuje nam Ziemia. Starannie dobieramy składniki pochodzące z ekologicznych upraw, minimalizując ingerencję człowieka i zachowując ich naturalne właściwości. Nasza filozofia opiera się na przekonaniu, że najbardziej efektywne i bezpieczne wsparcie dla organizmu pochodzi prosto z serca natury.

Jakość i Bezpieczeństwo
Jakość i bezpieczeństwo to fundamenty, na których zbudowana jest Glucorownowaga. Każdy produkt, zanim trafi do Państwa rąk, przechodzi rygorystyczne testy jakościowe i kontrole na każdym etapie produkcji. Od selekcji surowców, przez procesy produkcyjne w certyfikowanych zakładach, aż po finalne opakowanie – dbamy o każdy detal. Nasze suplementy są wolne od zbędnych wypełniaczy, sztucznych barwników i konserwantów. Stawiamy na czystość składu i maksymalną skuteczność, zapewniając Państwu produkty, którym można zaufać.

Transparentność
W Glucorownowaga wierzymy w pełną transparentność. Dzielimy się z Państwem pełną informacją o składnikach naszych produktów, ich pochodzeniu, procesach pozyskiwania i badaniach, które potwierdzają ich skuteczność i bezpieczeństwo. Każda etykieta jest jasna i zrozumiała, abyście mogli podejmować świadome decyzje dotyczące swojego zdrowia. Chcemy, abyście czuli się pewnie, wybierając nasze suplementy, wiedząc dokładnie, co dostarczacie swojemu organizmowi i dlaczego. Państwa zaufanie jest dla nas najważniejsze.

Nasz Zespół Ekspertów
Poznaj ludzi, którzy stoją za naszymi innowacyjnymi formułami i z pasją pracują nad tworzeniem produktów najwyższej jakości. Nasz zespół to połączenie doświadczenia, wiedzy naukowej i głębokiego zaangażowania w misję Glucorownowaga.

Dr Anna Kowalska
Dietetyk Kliniczny i Specjalista ds. Żywienia
Dr Anna Kowalska jest czołową dietetyczką kliniczną z ponad 15-letnim doświadczeniem w dziedzinie żywienia i metabolizmu. Jej specjalizacją jest wpływ diety na poziom glukozy we krwi oraz wspieranie naturalnej równowagi organizmu. W Glucorownowaga odpowiada za opracowywanie formuł produktów pod kątem ich wartości odżywczych i synergistycznego działania składników.

Prof. Jan Nowak
Biochemik i Kierownik Działu Badań
Profesor Jan Nowak to wybitny biochemik z wieloletnim stażem naukowym, specjalizujący się w naturalnych związkach bioaktywnych. Jego praca koncentruje się na identyfikacji i izolacji składników roślinnych o potwierdzonym działaniu prozdrowotnym. W Glucorownowaga kieruje działem badań i rozwoju, dbając o naukową rzetelność i innowacyjność naszych produktów.

Magdalena Wiśniewska
Specjalista ds. Kontroli Jakości
Magdalena Wiśniewska to nasza ekspertka od kontroli jakości, z ogromnym doświadczeniem w przemyśle farmaceutycznym i suplementów diety. Jest odpowiedzialna za wdrażanie i nadzorowanie rygorystycznych standardów jakości na każdym etapie produkcji. Dzięki jej pracy, mają Państwo pewność, że każdy produkt Glucorownowaga spełnia najwyższe normy bezpieczeństwa i czystości.
Kontrola Jakości
W Glucorownowaga, kontrola jakości to nie tylko proces, to nasza obsesja i obietnica wobec Państwa. Rozumiemy, że zaufanie buduje się na pewności, dlatego każdy etap powstawania naszych produktów jest monitorowany z najwyższą starannością i precyzją. Nasz system kontroli jakości jest wieloetapowy i obejmuje wszystko – od momentu pozyskania surowców, aż po finalny produkt, który trafia w Państwa ręce.
Selekcja i Testowanie Surowców
Wszystkie surowce używane w naszych suplementach pochodzą od sprawdzonych dostawców, którzy spełniają nasze rygorystyczne kryteria jakości. Każda partia surowca jest poddawana szczegółowym testom laboratoryjnym, aby upewnić się, że jest wolna od zanieczyszczeń, metali ciężkich, pestycydów i mikroorganizmów. Sprawdzamy również ich autentyczność i stężenie składników aktywnych, aby zagwarantować maksymalną skuteczność.
Proces Produkcji i Certyfikacja
Nasze produkty są wytwarzane w nowoczesnych zakładach, które posiadają certyfikaty GMP (Good Manufacturing Practices) oraz HACCP. Te międzynarodowe standardy zapewniają, że proces produkcji jest kontrolowany na każdym etapie, minimalizując ryzyko błędów i zanieczyszczeń. Regularne audyty zewnętrzne potwierdzają nasze zaangażowanie w utrzymanie najwyższych standardów produkcyjnych. Dbamy o sterylność, precyzję dawkowania i optymalne warunki przechowywania.

Testy Produktu Gotowego
Po zakończeniu procesu produkcji, każda partia gotowego produktu jest ponownie testowana. Sprawdzamy nie tylko czystość mikrobiologiczną i brak zanieczyszczeń, ale także potwierdzamy zgodność z deklarowanym składem i datą ważności. Przeprowadzamy testy stabilności, aby upewnić się, że produkt zachowuje swoje właściwości przez cały okres przydatności do spożycia. Tylko produkty, które przejdą wszystkie te rygorystyczne kontrole, są dopuszczane do sprzedaży. Państwa zdrowie i bezpieczeństwo są dla nas priorytetem, dlatego nie idziemy na żadne kompromisy w kwestii jakości.
